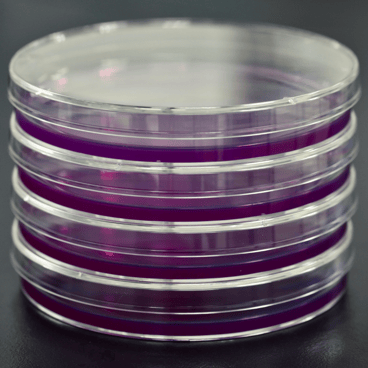
agar

USP <797> FAQs: Media Kits
- By: Rhonda Lintner, MPH, B.S.
- Tags: Media Kits, USP 797

Lately, the Pace® microbiology team has been fielding a lot of questions on how to interpret and implement different aspects of the revised USP <797> standard. Here are some of the most frequently asked questions regarding the use of sampling media kits.
Q: Can you tell me which media kits I should use?
A: Although Pace® supplies media kits and media kit subscriptions, we can’t advise customers on which kits to order. That’s because the revised USP <797> sampling requirements are based on each facility’s risk assessment and the sampling protocol/aseptic technique involved. When in doubt, consult the USP <797> chapter or work with a compliance specialist with expertise in that area.
Once you determine which media kits are required, we can help make ordering easier and more cost-effective with our media subscription plans. These subscriptions have the added benefit of helping to ensure you’re never out of compliance simply because you ran out of sampling media. Email us for more information and pricing on our media kit subscriptions.
Q: Can I sample using media kits with different lot numbers?
A: Lot numbers are assigned by the manufacturer and designate a specific production run. In other words, all media with the same lot numbers were manufactured and tested together. You can sample using media kits with different lot numbers, but in that case, you need to run a control per lot number. When we fulfill media kit orders, we try to fill from the same lot whenever possible. That allows us to help simplify sampling for our customers.
A: Lot numbers are assigned by the manufacturer and designate a specific production run. In other words, all media with the same lot numbers were manufactured and tested together. You can sample using media kits with different lot numbers, but in that case, you need to run a control per lot number. When we fulfill media kit orders, we try to fill from the same lot whenever possible. That allows us to help simplify sampling for our customers.
While we’re talking about noting lot numbers, this may be a good time to discuss expiration dates. You should always inspect media, including expiration dates, upon receiving supplies. Then adjust your sampling plans and inventory management to make sure supplies expiring soonest are the ones that get used first. Remember, too, that the expiration date needs to account for shipping and incubation time at the lab. Plates that will expire en route to the lab should not be used.
Finally, its vital to store unused media properly to preserve viability. Hardy Diagnostics has a handy, one-page guide on how to store prepared culture media.
Q: What is a control?
A: Controls are used to validate the results of sampling. For every sampling event (or lot number when multiple lots are used), there are two types of controls: a positive control and a negative control. As soon as the pharmacy is ready to use a media sleeve, they should remove two plates without opening them. These plates are sealed and sent to the lab along with the other samples. When the lab receives the plates, the unopened negative control immediately goes into the incubator. The positive control is opened and inoculated with a bacterium such as E. coli and then incubated.
If nothing grows on the negative control, that proves the media in that lot was uncontaminated prior to sampling. The positive control proves the media in that lot is conducive to biological growth if any were introduced through sampling.
Q: Are there any other tips and tricks we should be aware of when using sample media?
A: Handling media to ensure the validity of your sampling program is pretty simple once you get the hang of it. Nevertheless, mistakes happen. When they do, they usually fall into one of two areas.
The first is failure to inspect the media before using it. As we noted above, you should always check expiration dates upon receipt and plan accordingly. However, even if the media has is not expired, visually inspect the media for freshness. If the agar is drying out and pulling away from the side of the plate, the device will not support biological growth. Also check for cracks in the plates that may have occurred during shipping,
The second area where mistakes can be made is in the handling and shipping of the samples to the lab. We put together a post with ten tips for packing and shipping of samples so they arrive safely: 10 Tips for Proper Shipping of USP 797.
Got questions?
If you have additional questions on USP <797> compliance and would like to get a perspective from the lab, reach out to us. If you need a quote or would like a more detailed, personalized discussion, you can also reach out to us through our contact form or by calling 877-648-9150.
